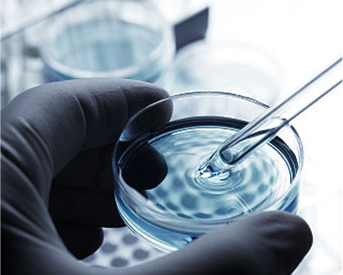

精选推荐

有机化学
有机金属试剂
合成试剂
分子砌块
催化剂
有机催化小分子
配体
专业溶剂
聚合物
无机化学
单质
无机盐
碳材料
氧化物
稀土化合物
纳米材料
生命科学
生化试剂
微生物培养类
细胞生物学类
分子生物学类
蛋白质与免疫
抗体
生化检测试剂盒
ELISA试剂盒
仪器耗材
通用仪器
称量仪器
检测仪器
分析仪器
常规耗材
生物耗材
分析耗材
安全防护

有机金属试剂
有机锌试剂
有机锂试剂
有机锡试剂
有机硅试剂
格氏试剂
有机铝
有机硼
合成试剂
氧化剂
还原剂
脱水试剂
手性助剂&手性拆分试剂
特殊气体
相转移试剂
路易斯酸
分子砌块
脂环
芳环
芳杂环
手性砌块
桥环
螺环
含氟砌块
专业溶剂
AR溶剂
色谱溶剂
超干溶剂
氘代溶剂
其他溶剂
稳定同位素
氘
碳13
氮15
硼同位素
氧18
亚磷酰胺类
2'-F亚磷酰胺单体
2'-O-Me亚磷酰胺单体
2'-O-MOE亚磷酰胺单体
2'-O-4'-C-Locked亚磷酰胺单体
3'-TrNH亚磷酰胺单体
PMO亚磷酰胺单体
Dye亚磷酰胺单体
单质
锂
钠
钾
铷
铯
铍
镁
More...
无机盐
铵盐
铋酸盐
草酸盐
次磷酸盐
醋酸盐
碲酸盐
碘酸盐
More...
卤化物
氟化物
氯化物
溴化物
碘化物
碳材料
石墨
活性炭
富勒烯
金刚石
石墨烯
石墨炔
碳纤维
More...
纳米材料
纳米金
纳米银
纳米纤维
磁性微球
二氧化硅微球
聚苯乙烯微球
上转换纳米材料
More...
材料科学
有机框架材料
聚合物/高分子试剂
电子材料
光学材料
磁性材料
通用仪器
液体处理
粉碎/混合/分离
箱体/真空
合成/纯化
清洗/净化
低温存储
加热/制冷
分析仪器
物性测定
光学设备
光谱/色谱/质谱
水质分析/气体检测
食品检测
常规耗材
称量/取样/加样
反应/连接/冷凝
加热/降温/温湿计
量器
研磨/分离/过滤
样品储存/样品管理
移液/分液
蒸发/干燥
分析耗材
样品前处理
色谱耗材
检测耗材
生化试剂
抗生素类
维生素类
激素类
碳水化合物及其衍生物
染色及显色试剂
酸、盐、糖
核酸及其衍生物
More...
微生物培养类
菌株
培养基
酵母缺陷型培养基
培养基成分
细胞生物学类
细胞培养试剂
细胞分离消化与裂解
细胞检测试剂
细胞凋亡检测试剂
细胞转染试剂
细胞染色与探针
细胞株系
细胞培养基
分子生物学类
核酸提取/纯化试剂
PCR相关试剂
qPCR相关试剂
凝胶电泳相关试剂
分子杂交试剂
常用重组质粒表达载体
限制性核酸内切酶
More...
蛋白质与免疫
蛋白提取与纯化
蛋白样品制备
蛋白检测与标记试剂
蛋白电泳试剂
重组蛋白类
免疫相关试剂
免疫分析试剂
抗体
一抗
二抗
内参抗体
免疫血清
生化检测试剂盒
氧化应激系列
辅酶/辅因子系列
能量代谢系列
碳水化合物系列
脂质代谢系列
氮代谢系列
其他生化试剂盒
More...
ELISA试剂盒
人
小鼠
大鼠
豚鼠
仓鼠
动物类
植物类
More...
生物材料
金属纳米材料
磁性微球
单分散微球
其它材料
标记服务与标记试剂盒
偶联试剂盒
大分子蛋白/抗体
小分子